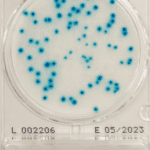
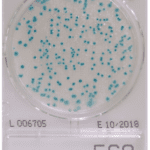
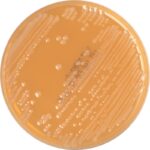
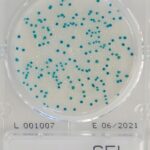
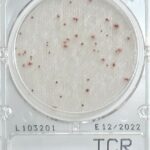
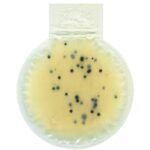
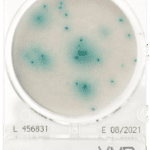
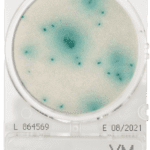
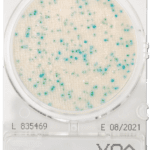
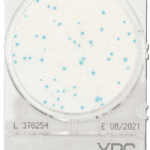
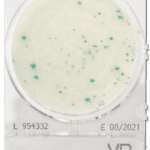
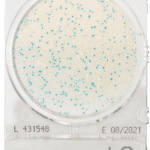
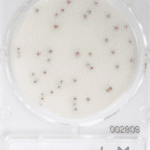
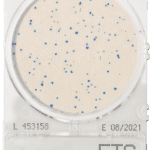
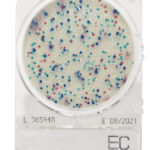
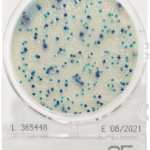

Filters Sort results
Reset Apply
Produit | Cible | Pack | Réf. | Quantité | |
|---|---|---|---|---|---|
| 06545-PBS-0200 | | | |||
| 06544-BPW-0200 | | | |||
| Coliform | | | | | |
| | | | | ||
| 450002-PBS-0500 | | | |||
| 69202-MYC-0048 | | | |||
| N/A | 05901-EM2-0100 | | | ||
| N/A | 05900-EM1-0100 | | | ||
| Lactobacilli | 05801-LIB-0100 | | | ||
| streptococci | 05814-FAM-0050 | | | ||
| Enterobacteriacae Salmonella | 05040-DHS-0300 | | | ||
| Aerobic and Anaerobic bacteria | 05629-TGC-0300 | | | ||
| N/A | 05516-0TP-0300 | | | ||
| Fungi | 05703-CGE-0100 | | | ||
| Bacillus cereus | 05282-NGK-0300 | | | ||
| Vibrio parahaemolyticus | 05135-XVP-0300 | | | ||
| Anaerobes | 05422-GAB-0300 | | | ||
| Anaerobes | 05426-GMM-0300 | | | ||
| M570-0LS-T125 | | | |||
| M572-0SL-T125 | | | |||
| M530-0CF-T125 | | | |||
| 450004-BPW-0500 | | | |||
| Coliforme | | | | | |
| 450001-NRS-0500 | | | |||
| Total count | | | | | |
| Anaerobes | 05409-CCA-0300 | | | ||
| Anaerobes | 05404-CWA-0100 | | | ||
| N/A | 05815-PAM-0050 | | | ||
| N/A | 05215-SPB-0100 | | | ||
| Vibrio parahaemolyticus | 05206-APW-0100 | | | ||
| Anaerobes | 05430-BLA-0300 | | | ||
| Brucella Neisseria pneumococci streptococci | 05630-TSB-0300 | | | ||
| Anaerobes | 05433-GBM-0100 | | | ||
| Anaerobes | 05420-GAM-0300 | | | ||
| Lactobacilli | 05819-B12-0050 | | | ||
| Lactobacillus arabinosus | 05818-BAM-0050 | | | ||
| Yeast and mould | | | | | |
| Yeast and mould | | | | | |
| Staphylococcus aureus | | | | | |
| Bacillus cereus | | | | | |
| Vibrio parahaemolyticus | | | | | |
| Total count | | | | | |
| Salmonella | | | | | |
| Pseudomonas aeruginosa | | | | | |
| Listeria species | | | | | |
| Listeria monocytogenes | | | | | |
| Enterococci | | | | | |
| Enterobacteriacae | | | | | |
| E. coli and coliform | | | | | |
| Coliform | | | | | |
| Heterotrophic bacteria in water | | | | | |
| 05592-EBP-080 | | | |||
| 05593-EB0-080 | | | |||
| 06517-EBQ-018 | | | |||
| 06514-EBC-001 | | |